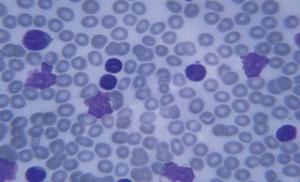
Высокоточное направленное лечение рака

What is tuberculosis?
Tuberculosis (say: too-burr-cue-low-sis), also called TB, is an...
What is Crohn's disease?
Разработано эффективное лекарство для точечного уничтожения клеток рака
Разработано эффективное лекарство для точечного уничтожения клеток рака
 Самой тяжелой задачей во время лечения онкологических заболеваний является уничтожение опухоли и сохранение...
Самой тяжелой задачей во время лечения онкологических заболеваний является уничтожение опухоли и сохранение...
 Делать детей после смерти: Это возможно, но этично ли?
Делать детей после смерти: Это возможно, но этично ли?
 Этично ли использовать сперму погибшего мужчины для...
Этично ли использовать сперму погибшего мужчины для...
Your endocrine system includes eight major glands throughout your body. These glands make hormones. Hormones are chemical messengers. They travel through your bloodstream to tissues or organs....
 What is cirrhosis?
What is cirrhosis?
In people who have cirrhosis, the cells of the liver are damaged and can’t repair themselves. As liver cells die, scar...
 Бег так же безопасен для суставов как и ходьба
Бег так же безопасен для суставов как и ходьба
 Кажется ли вам иногда, что вашим ногам предписано бегать, но вместо этого вы ходите и избегаете лишнего напряжения, чтобы защитить собственные ...
Кажется ли вам иногда, что вашим ногам предписано бегать, но вместо этого вы ходите и избегаете лишнего напряжения, чтобы защитить собственные ...
С 30 июня по 1 июля 2015 года на базе АО «Национальный научный кардиохирургический центр» прошел мастер-класс по...



 Верховный суд США единогласным решением ...
Верховный суд США единогласным решением ...